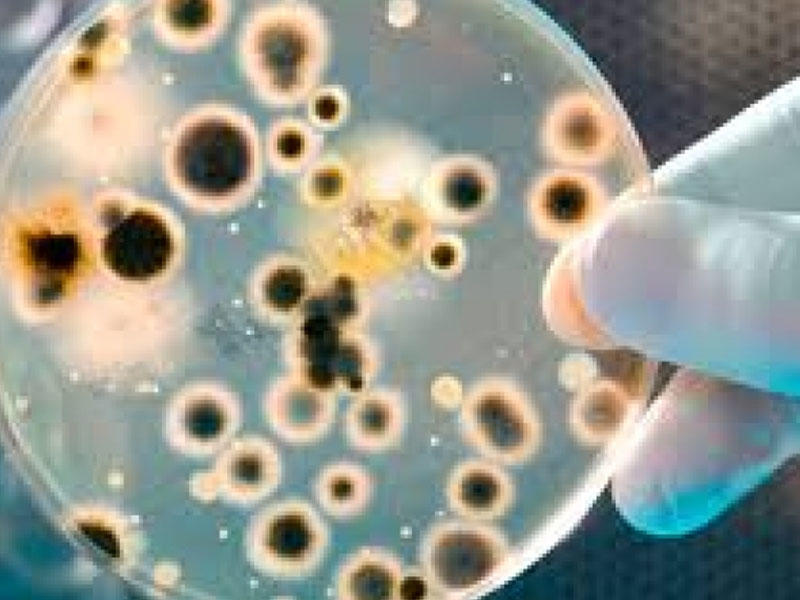
Yeni nəsil antibiotiklər kəşf olunub: İndiki dərmanlara davamlı supermikrobları zərərsizlədirə bilir

Yeni nəsil antibiotiklər kəşf olunub: İndiki dərmanlara davamlı supermikrobları zərərsizlədirə bilir
Supermikroblara qalib gəlməyə ikiqat fəaliyyətli-yeni nəsil antibiotiklər kömək edəcək.
Supermikroblara qalib gəlməyə ikiqat fəaliyyətli-yeni nəsil antibiotiklər kömək edəcək.
Bütün məlum antibiotiklərə davamlı bakteriyaları (supermikrobları) öldürürən və həm də immun sistemini onlara qarşı mübarizə aparmağa yönəldən yeni birləşmə sinfi aşkar edilib.
Milli.Az e-tibb.az-a istinadən bildirir ki, ABŞ-dan olan bir qrup alim (Wistar Biotibbi Araşdırmalar İnstitutu) tərəfindən bununla bağlı aparılan araşdırmanın nəticələri "Nature" jurnalında dərc olunub.
Bütün məlum antibiotiklərə qarşı davamlı patogen bakteriyaların (supermikrobların) fəlakətli artımı səhiyyədə qlobal böhrana səbəb olub. Xüsusilə COVİD-19 pandemiyası zamanı bu böhran kəskinləşib və bunun qarşısını almaq üçün yeni nəsil antimikrob preparatlara böyük ehtiyac var. Bu dərmanlar artıq mövcud antibiotiklərdən fərqli prinsiplərlə işləməlidir.
Farux Dotivala (Farokh Dotyvala) və həmkarları unikal xüsusiyyətlərə malik kimyəvi birləşmələrin yeni bir sinfini aşkar ediblər. Onlar yalnız supermikrobların fəaliyyətini maneə törətməklə deyil, eyni zamanda immunitet sisteminin hüceyrələrini eyni istiqamətdə işləməyə məcbur etməyə qadirdir. Alimlər yeni nəsil bu cür dərmanları "ikiqat təsirli immuno-antibiotiklər" adlandırıblar.
Söhbət xüsusilə, İspH- fermentini bloklayan İsph- inhibitorları-birləşmələrdən gedir. Bu protein izoprenoidlərin (çox patogen bakteriyaları hüceyrələrinin yaşaması mümkün olmayan maddələr) biosentezində əsas rol oynayır. "Insanlaşdırılmış" siçanlar (gen mühəndisliyi sayəsində insan genləri və hüceyrələri olan heyvanlar) üzərində aparılan eksperimentlər göstərib ki, İspH-inhibitorları həmçinin insan T-hüceyrələrini aktivləşdirərək, bakteriyalara hücum etməklə müdafiənin "ikinci xəttini" təmin edir. Nəticədə, mikroblar iki cəbhədə işləməli olurlar ki, bu da davamlı inkişafa mane olur.
Milli.Az /news.milli.az










 8 mart – Beynəlxalq Qadınlar günü münasibətilə təbrik
8 mart – Beynəlxalq Qadınlar günü münasibətilə təbrik Yuxuda sevdiyin insanı görmək
Yuxuda sevdiyin insanı görmək Kişiləri ehtiraslandıran sözlər
Kişiləri ehtiraslandıran sözlər İdeal Dieta: 1 həftəyə 5 kq arıqla!
İdeal Dieta: 1 həftəyə 5 kq arıqla! Qara zirə (Çörək otunun) faydaları
Qara zirə (Çörək otunun) faydaları Qarazirə hər dərdin çarəsi olan bitki
Qarazirə hər dərdin çarəsi olan bitki Ən güclü təbii antibiotik: Udi hindi bitkisinin faydaları
Ən güclü təbii antibiotik: Udi hindi bitkisinin faydaları Röya Aygünün mahnısını oxuyacaq
Röya Aygünün mahnısını oxuyacaq Mənim daşım yaman ağırdır
Mənim daşım yaman ağırdır İsveçli müğənni Avroviziyanı boykot etdi
İsveçli müğənni Avroviziyanı boykot etdi Konsert məni qocaldır
Konsert məni qocaldır Mumiya'nın dördüncü sezonu çəkiləcək
Mumiya'nın dördüncü sezonu çəkiləcək "Avroviziya Asiya" keçiriləcək
"Avroviziya Asiya" keçiriləcək Asqırmağı saxlamaq təhlükəlidir - Həkimdən xəbərdarlıq
Asqırmağı saxlamaq təhlükəlidir - Həkimdən xəbərdarlıq